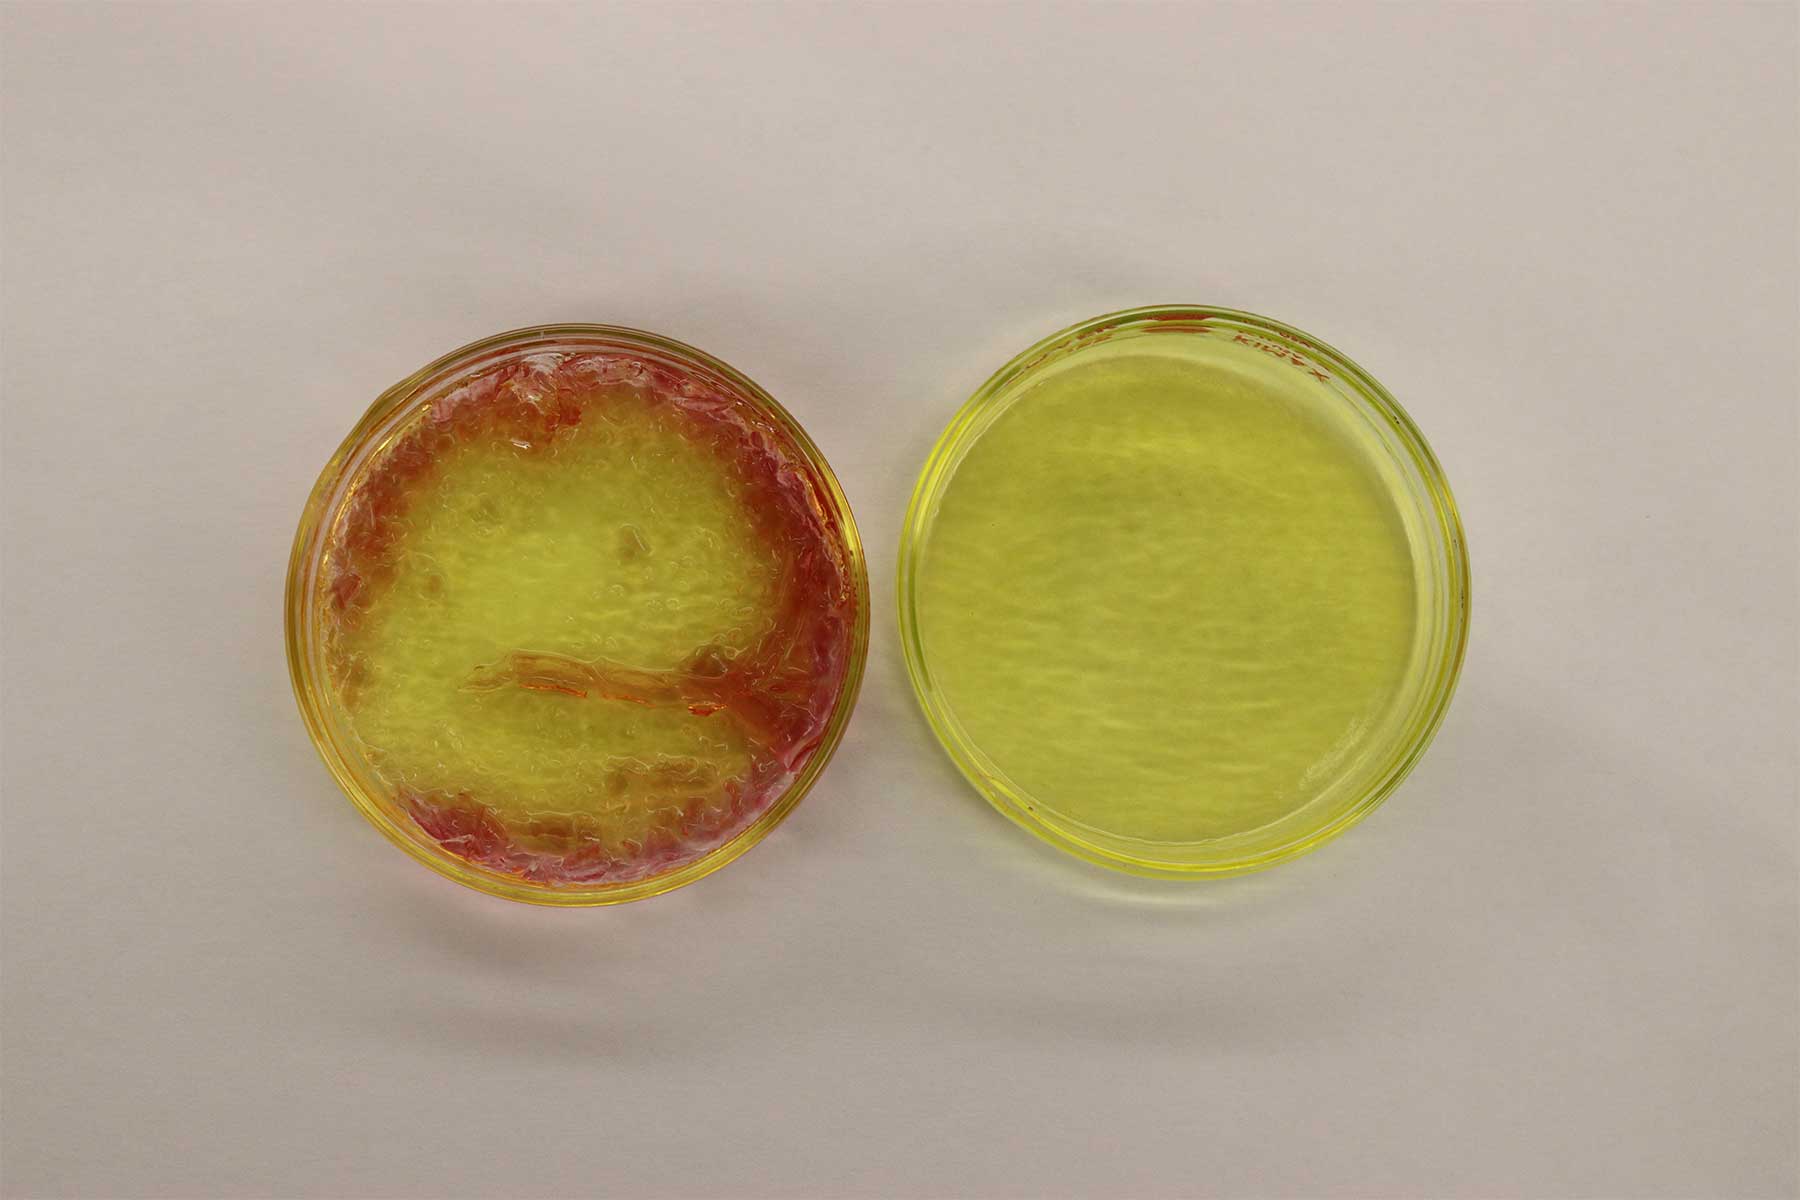

Research Opportunities with Dr. Mike Ducey
Analytical Applications of Room Temperature Ionic Liquids
Room temperature ionic liquids (RTILs) are a class of organic salts with unique and tuneable solubility properties. With zero vapor pressure and low toxicity, they are excellent for ‘green chemistry’ applications. Understanding and applying these unique properties allow for the development of designer applications of chemical sensors and separations.
Research in the Ducey group is focused in three areas:
- Understanding the fundamental relationships between the structure of RTILs and their function.
- The development of RTIL based optical sensors.
- Applications of RTILs in chemical separations including high-performance liquid chromatography and thin-layer chromatography.
Contact Dr. Ducey

Dr. Mike Ducey, Professor
B.S., University of Kansas
Ph.D., University of Michigan
(816) 271-4391
ducey@missouriwestern.edu
Agenstein Hall 332